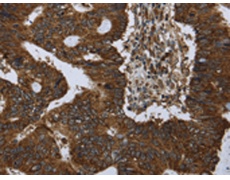
一抗

中文名稱: 兔抗PPP1R13L多克隆抗體
英文名稱: Anti-PPP1R13L rabbit polyclonal antibody
別 名: RAI, RAI4, IASPP, NKIP1
相關類別: 一抗
儲 存: 冷凍(-20℃)
宿 主: Rabbit
抗 原: PPP1R13L
反應種屬: Human, Mouse
標 記 物: Unconjugate
克隆類型: rabbit polyclonal
技術規(guī)格
|
Background: |
RelA-associated inhibitor is a protein that in humans is encoded by the PPP1R13L gene. Regulator that plays a central role in regulation of apoptosis and transcription via its interaction with NF-kappa-B and p53/TP53 proteins. Blocks transcription of HIV-1 virus by inhibiting the action of both NF-kappa-B and SP1. Also inhibits p53/TP53 function, possibly by preventing the association between p53/TP53 and ASPP1 or ASPP2, and therefore suppressing the subsequent activation of apoptosis. Interacts with RELA NF-kappa-B subunit and with SP1 via its C-terminus part. Interacts with p53/TP53, TP63 and TP73. |
|
Applications: |
ELISA, WB, IHC |
|
Name of antibody: |
PPP1R13L |
|
Immunogen: |
Synthetic peptide of human PPP1R13L |
|
Full name: |
protein phosphatase 1, regulatory subunit 13 like |
|
Synonyms: |
RAI, RAI4, IASPP, NKIP1 |
|
SwissProt: |
Q8WUF5 |
|
ELISA Recommended dilution: |
2000-5000 |
|
IHC positive control: |
Human colon cancer and Human liver cancer |
|
IHC Recommend dilution: |
50-200 |
|
WB Predicted band size: |
89 kDa |
|
WB Positive control: |
MCF7 and hela cells |
|
WB Recommended dilution: |
500-2000 |


 購物車
購物車 幫助
幫助
 021-54845833/15800441009
021-54845833/15800441009